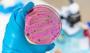
Görünmeyen tehlike! Bakteriler kimyasalları saklıyor

Türkiye ile Nijerya savunma iş birliği ileri bir aşamaya geçiyor

The Guardian Nigerian News'in iddiasına göre Türkiye ile Nijerya arasındaki savunma iş birliği yeni bir aşamaya giriyor. Antalya'daki görüşmelerin ardından, Nijerya'da askeri eğitim tesisi kurulması, personelin eğitilmesi, teknoloji transferi ve İHA tedarikini kapsayan kapsamlı bir ortaklık planı öne çıkıyor.
The Guardian Nigerian News'in haberine göre, Nijerya ile Türkiye arasında savunma alanında kapsamlı bir iş birliği için önemli bir adım atıldı. İddiaya göre iki ülke, Nijerya'nın güvenlik altyapısını güçlendirmek amacıyla ülkede askeri eğitim tesisi kurulması konusunda mutabakata vardı.
ANTALYA'DA KRİTİK TEMAS
Söz konusu gelişmenin, Antalya Diplomasi Forumu 2026 sırasında yapılan görüşmelerin ardından gündeme geldiği belirtildi.
Nijerya Savunma Bakanı Christopher Musa ile Milli Savunma Bakanı Yaşar Güler arasında gerçekleştirilen görüşmelerde, savunma iş birliğinin genişletilmesi, eğitim faaliyetleri ve teknoloji transferi konuları ele alındı.

Nijerya Savunma Bakanlığı'nın açıklamalarına dayandırılan haberde, kurulması planlanan tesisin uzun vadeli bir eğitim ve kapasite geliştirme merkezi olarak hizmet vereceği ifade edildi.
ASKERİ EĞİTİM VE KAPASİTE ARTIŞI
Anlaşma kapsamında Nijeryalı askerlerin; özel operasyonlar, terörle mücadele, istihbarat koordinasyonu, İHA'lara karşı savunma ve el yapımı patlayıcılara karşı mücadele gibi alanlarda eğitim alması öngörülüyor.
Ayrıca Birleşmiş Milletler görevleri öncesi hazırlık eğitimlerinin de bu programın parçası olacağı aktarıldı.
Haberde, ilk aşamada bir grup askeri personelin eğitim, dil öğrenimi ve saha tatbikatları için Türkiye'ye gönderilmesinin planlandığı bilgisine yer verildi.
TEKNOLOJİ VE ORTAK ÜRETİM VURGUSU
İş birliğinin yalnızca eğitimle sınırlı kalmayacağı; savunma teknolojisi transferi, ortak üretim projeleri ve modern harp kabiliyetlerinin geliştirilmesini de kapsayacağı belirtildi.
İki ülkenin gözetleme sistemleri, insansız hava araçları ve uydu tabanlı izleme teknolojileri üzerinde birlikte çalışmasının hedeflendiği ifade edildi.
Ayrıca sınır güvenliği, istihbarat paylaşımı ve devlet dışı silahlı gruplara karşı ortak stratejilerin geliştirilmesi de planlanan başlıklar arasında yer alıyor.

İHA VE DENİZ PLATFORMLARI GÜNDEMDE
Habere göre iş birliği, Nijerya Hava Kuvvetleri'nin kapasitesini artırmaya yönelik bakım, lojistik ve eğitim desteklerini de içeriyor. Helikopter ve insansız hava araçlarının tedariki de gündemdeki başlıklar arasında. Deniz kuvvetleri alanında ise eğitim değişim programları ve kıyı güvenliğini güçlendirecek platformların temini değerlendiriliyor.
"DÖNÜM NOKTASI" VURGUSU
Nijerya Savunma Bakanı Musa, anlaşmayı iki ülke ilişkileri açısından "dönüm noktası" olarak nitelendirerek, iş birliğinin ülkesinin güvenliğine somut katkılar sağlayacağını ve ulusal hedeflerle uyumlu olduğunu ifade etti.
- Popüler Haberler -

Katar: Hürmüz krizi devam ederse bu bölgesel boyuttan çıkarak küresel bir hal alır

Sina'da 35 metre çapında gizemli yapı! Tarih yeniden yazılıyor
Görünmeyen tehlike! Bakteriler kimyasalları saklıyor

İsrail asıllı Amerikalı Profesör böyle niteledi: Gazze'de yaşananlar Holokost değil, özel bir soykırım

3,6 milyar yıllık Mars kayalarında şaşırtan atmosfer bulgusu

Okyanuslarda avcı türler için alarm! Yaşanabilir alanlar hızla daralıyor












